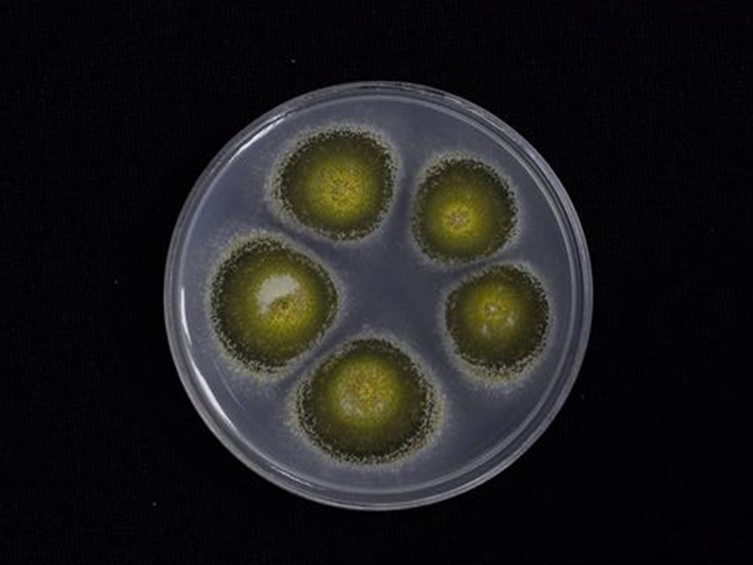

Holotype:
THAILAND, Kalasin Province, Khok Pa Si Community forest, 15 Jun. 2012, K. Tasanathai, S. Mongkolsamrit, P. Srikittikulchai, A. Khonsanit, W. Noisripoom, holotype BBH 34585, ex-type living culture BCC 53582.
Habitat:
Buried in the ground.
Host:
Coleoptera larva.
Description:
 Stromata simple to sparingly branched, yellow brown when young turning olive green to greenish brown with age, dark green ostioles. Rhizoids flexuous, up to 30 cm buried deep in the ground. Stipe of the stroma brownish yellow to olive green, up to 0.5 cm broad. Sterile stipe emerging from the ground, cylindrical, mustard yellow to olive green, 3-5 cm long, 0.5 cm wide. Fertile part clavate, 25-30 × 3-5 mm.
Stromata simple to sparingly branched, yellow brown when young turning olive green to greenish brown with age, dark green ostioles. Rhizoids flexuous, up to 30 cm buried deep in the ground. Stipe of the stroma brownish yellow to olive green, up to 0.5 cm broad. Sterile stipe emerging from the ground, cylindrical, mustard yellow to olive green, 3-5 cm long, 0.5 cm wide. Fertile part clavate, 25-30 × 3-5 mm.  Perithecia flask-shaped, immersed, oblique in arrangement, 700-800 × 250-350 μm, each wall with a layer of closely arranged parallel hyphae, 20-30 μm thick.
Perithecia flask-shaped, immersed, oblique in arrangement, 700-800 × 250-350 μm, each wall with a layer of closely arranged parallel hyphae, 20-30 μm thick.  Asci hyaline, cylindrical, 500-650 × 4-5 μm, with a prominent apical cap, 5-8 × 3-5 μm.
Asci hyaline, cylindrical, 500-650 × 4-5 μm, with a prominent apical cap, 5-8 × 3-5 μm.  Ascospores filiform, hyaline, without septations and not fragmenting into part-spores, 400-500 × 1-1.5 μm.
Ascospores filiform, hyaline, without septations and not fragmenting into part-spores, 400-500 × 1-1.5 μm.
Culture characteristics:
Colonies on PDA attaining a diam of 10 mm in 14 d, at first white turning pale yellow green with the production of conidia, velvety to funiculose, reverse cream to yellow. Phialides cylindrical, narrowing at the tip, to lanceolate. Conidia cylindrical with rounded ends, forming long chains, 6–7 × 2–3 μm.
Colonies on PDA attaining a diam of 10 mm in 14 d, at first white turning pale yellow green with the production of conidia, velvety to funiculose, reverse cream to yellow. Phialides cylindrical, narrowing at the tip, to lanceolate. Conidia cylindrical with rounded ends, forming long chains, 6–7 × 2–3 μm.
Reference:
Mongkolsamrit S, Khonsanit A, Thanakitpipattana D, et al. (2020). Revisiting Metarhizium and the description of new species from Thailand. Studies in Mycology 95: 171–251.
DOI: https://doi.org/10.1016/j.simyco.2020.04.001Species |
Strain |
Compound |
Pubchem CID |
Biological activity |
Reference |
|---|
|
Strain |
5'TEF | ITS | LSU | SSU | TEF1 |
|---|---|---|---|---|---|
| BCC 53581 | - | - | - | - | - |
| BCC 53582 | - | KC011179 | KC011183 | KC011175 | KC011189 |